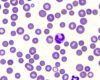
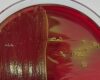
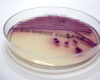
Laboklin: Salmonellen in Reinkultur
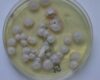
Laboklin: Tr. mentagrophytes Kultur Unterseite
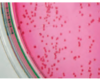
Laboklin: Bordetella bronchiseptica – Reinkultur auf Selektivnährboden
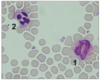

Alternative Alternative zur Antibiose: Autovakzinen bei chronischen Haut-, Ohr- und Atemwegsinfektionen von Haustieren.
Feline Hyperthyreose: Symptome, Diagnostik, neue Parameter, Therapieoptionen
Durchfall, Kotabsatz mit erhöhtem Wassergehalt und/oder einer erhöhten Frequenz, ist auch bei Kleinsäugern einer der häufigsten Vorstellungsgründe. Der Therapieerfolg ist abhängig vom Wissen um die tierartspezifischen Durchfallursachen und die systematische Aufarbeitung.
Chronischer Nasenausfluss bei Hund und Katze: Diagnostik, Differentialdiagnosen von Rhinitis über Mykosen zu Neoplasien
Ergussanalyse: Transsudat, Exsudat, Zytologie, Zellzahl, weitere Diagnostik
Akute-Phase-Protein bei Hund und Katze: diagnostische Bedeutung von CRP, SAA, AGP und Co. für die Praxis
Aktuelle Expertenrunde zum Cushing‑Syndrom: Fachwissen zu Symptomen, Diagnostik und Therapie bei Hund und Katze – kompakt und praxisnah erklärt.
Bei der präzisen Diagnose der kaninen Hypothyreose liefern die rT3-Messung sowie LC-MS/MS-basierte Analysen besonders in Zweifelsfällen entscheidende Informationen.
Spontantumoren bei Meerschweinchen: Häufigkeit, Lokalisation, Histologie
Experteneinschätzungen zu Symptomen, Diagnostik und Therapie der granulozytären Anaplasmose bei Kleintieren und Pferden
Bedeutung Tränkwasser für die Rindergesundheit und Parameter bei der Analyse inkl. Richtwerte
Intraokuläre melanozytäre Tumore bei Hund und Katze: Klinik, Diagnose, Prognose
Intraokuläre melanozytäre Tumore bei Hund und Katze: Klinik, Diagnose, Prognose
Experten geben Einblick in Diagnostik, Prognose und Therapiemöglichkeiten
Transitphase beim Rind: Labordiagnostik zur Früherkennung von Stoffwechselstörungen und Immunstatus
Giardien, wann ist welcher Test sinnvoll?
Informationen über das Feline Leukosevirus (FeLV) und Feline Immundefizienzvirus (FIV) – wichtige Details zur Diagnose, Prävention und Prognose.
Optimale Präanalytik für Kleinsäuger bei LABOKLIN Bad Kissingen. Vermeiden Sie präanalytische Fallen und verbessern Sie die Probenqualität für aussagekräftige Ergebnisse.
LABOKLIN Expertenrunde zur Epilepsie: Fachvorträge von Experten über Ursachen, Diagnostik, genetische Prädispositionen und Therapien bei Hund und Katze.
Erfahren Sie alles über die BRAF-Mutation und den BRAF comp. Test beim Hund - wie diese Tests zur Diagnose von Karzinomen der Harnblase und Prostata beitragen.
2024
Erfahren Sie alles über Leukämien bei Hunden und Katzen, einschließlich Diagnose, Symptome und Behandlungsmöglichkeiten. Informieren Sie sich über die Unterschiede zwischen lymphatischen und myeloischen Leukämien sowie akuten und chronischen Formen.
Kennen Sie diese Situationen aus der Praxis? Ein acht Wochen alter Welpe entwickelt nach dem Setzen des Chips ein großes Hämatom? Eine Hündin zeigt verstärkte Blutungen in der Läufigkeit und bei der Kastration kommt es zu ungewöhnlichen Nachblutungen?
Kaninchen, Meerschweinchen, Ratte und Co. sind beliebte Haustiere und täglich Patienten in unseren Kleintierpraxen.
Hier finden Sie den aktuellen Stand zu Bluttests, die einen wichtigen Beitrag zu Diagnostik und Monitoring von Tumorerkrankungen leisten können.
Die Laboklin Expertenrunden gehören nun schon fest zum Programm und sind sehr beliebt. Renommierte Experten geben Antworten auf Fragen rund um spannende und aktuelle Themen. Die wichtigsten Auszüge zur CNE haben wir hier für Sie zusammengestellt.
Feline Coronaviren (FCoV) sind weltweit verbreitet und wahrscheinlich jedem im tierärztlichen Praxisalltag schon über den Weg gelaufen. Dabei muss zwischen zwei Biotypen unterschieden werden.
Kleinsäuger sind Flucht- und Beutetiere. Schwere Erkrankungen müssen lange unerkannt bleiben, da die Tiere sonst leicht Opfer von Fressfeinden werden!
Rodentizide („Rattengifte“) sind immer wieder Ursache von lebensbedrohlichen Vergiftungen bei Hunden und Katzen.
Diagnostik und Prognosestellung von Mastzelltumoren: ein Überblick über Zytologie, Pathohistologie, Ki-67-Proliferationsmarker und c-Kit-Mutationsstatus.
Die Echinokokkose ist eine der wichtigsten durch Cestoden verursachten Zoonosen. In Deutschland ist sie beim Menschen und einigen Tierarten, u. a. dem Hund, meldepflichtig.
Ist das Tier kastriert oder nicht kastriert? Diese Frage stellt sich immer dann, wenn entweder Fundtiere oder Tierheimtiere mit fehlenden Kastrationsnarben und unklarem Kastrationsstatus vorgestellt werden oder ältere, vermeintlich kastrierte Tiere wieder typisches sexuelles Verhalten wie Aufreiten, Rammeln, Jagen und vermehrt Aggression zeigen.
Als „Lungenwürmer“ bei Hund und Katze werden in erster Linie bestimmte Parasiten aus der Überfamilie der Metastrongyloidea bezeichnet, deren adulte Stadien in der Lunge ihrer Wirte leben.
Die Laboklin-Expertenrunde ist mittlerweile ein Begriff. Dabei beschäftigen sich eingeladene Experten in einer moderierten Diskussion intensiv mit den Fragen des Publikums.
2023
Clinical Consensus Statements und Guidelines stellen von einem Expertenkomitee herausgegebene einheitliche Konsenserklärungen und Leitlinien in der Medizin dar.
Intoxikationen von Hunden und Katzen sind immer wieder Thema in der Praxis ...
Dermatophyten sind weltweit verbreitete, keratinophile, fadenförmige Pilze, die Haut, Haare und Krallen befallen...
Parasiten haben unterschiedliche Überlebensstrategien entwickelt.
Verdauungsstörungen sind ein häufiger Vorstellungsgrund in der tierärztlichen Praxis.
Die Hypothyreose ist eine häufig vorkommende Endokrinopathie beim Hund. Wir haben Ihnen wichtige Fragen und Antworten aus der Expertenrunde zum Thema Hypothyreose zusammengestellt.
Die gastrointestinale Mikrobiota ist eine komplexe Gemeinschaft von Mikroorganismen, die den Verdauungstrakt besiedelt und eine wichtige Rolle für die Gesundheit und das Wohlbefinden der Tiere spielt.
Täglich kommen Katzenpatienten mit Atemwegsinfektionen in die Praxis.
Eine Entzündung in jedem Teil des Ohrs wird Otitis genannt.
„Das letzte Kind trägt Fell“ – diese gängige gesellschaftliche Ansicht führt dazu, dass Hunde häufig als Familienmitglieder sehr eng mit uns Menschen zusammenleben.
Die chronische Enteropathie – ein komplexes Thema, das viele Fragen aufwirft.
Mehrmals im Jahr laden wir zu einer spannenden Diskussion unter Experten ein.
Schon lange sind Coronaviren aufgrund der weltweiten Verbreitung und Empfänglichkeit verschiedenster Spezies ein wichtiges Thema in der Tiermedizin.
2022
Brucella (B.) canis ist der Erreger der Hundebrucellose...
Eine Hämolyse vermuten wir insbesondere bei regenerativen Anämien, wenn ein Blutverlust ausgeschlossen wurde
Wie bei allen Hautproblemen ist auch bei der Katze eine gründliche Anamnese das wichtigste Instrumentarium, um zu einer Diagnose zu kommen.
Bei ca. 0,5 – 1% der caninen und felinen Patienten, die mit urologischen Problemen in deutschen Tierarztpraxen vorgestellt werden...
Parvoviren spielen bei verschiedenen Tierarten als Infektionserreger eine bedeutende Rolle.
Akute-Phase-Proteine (APP) sind ein wichtiger Bestandteil des körpereigenen unspezifischen Abwehrsystems.
Das feline Asthma gehört mit dem felinen atopischen Hautsyndrom (feline atopic skin syndrome, FASS), das die kutanen Reaktionsmuster der Katze...
Die Parameter, die wir für die Nierenfunktionsdiagnostik nutzen, sind so genannte Biomarker.
Eine erhöhte Proteinausscheidung über den Urin bei Hund und Katze ist pathologisch....
Tumor- und Infektionsdiagnostik beim Kleinsäuger mittels Zytologie und Histopathologie - auch Spezialfärbungen und Immunhistologie sind bei Laboklin etabliert
Wo wären wir diagnostisch ohne Labortests?
2021
Die feline infektiöse Peritonitis (FIP) entwickeln ca. 1 – 3% (1) bzw. 5 – 12% (2, 3) der Katzen...
Odontogene Tumoren und Zysten in der Maulhöhle von Hund und Katze – erfahren Sie alles über Diagnostik, Therapie und Prognose.
Unsere Kenntnisse über Infektionserreger, die bei Reptilien vorkommen, sind in den letzten Jahren stark gewachsen.
Hunde mit Otitis externa (O. e.) werden häufig in der Kleintierpraxis vorgestellt.
Die Diagnose von Infektionskrankheiten bei Kaninchen ist nicht immer einfach...
Reptilien, die als Haustiere gehalten werden, werden in der Praxis häufig aufgrund unterschiedlichster Hautveränderungen vorgestellt.
Die Haut als größtes Organ des Körpers ist für diverse Untersuchungen leicht zugänglich, dennoch kann sich die diagnostische Aufarbeitung von dermatologischen Patienten überaus frustrierend gestalten.
Den relevantesten in Europa vorkommenden Vertreter des Genus Orthopoxvirus stellt das Kuhpockenvirus („cowpox“ virus) dar...
Tumoren bei jungen Hunden: Häufigkeit, Arten und Bedeutung von zytologischen und histopathologischen Untersuchungen für Diagnose und Prognose.
Die Zöliakie des Menschen ist eine Gluten-induzierte Enteropathie, die durch einen spezifischen genetischen Genotyp (HLA-DQ2/ HLA-DQ8 Gene)...
Prinzipiell stehen für die Therapie des Hyperadrenocortizismus beim Hund folgende Verfahren zur Wahl:
2020
Neoplasien bei der Bartagame – denken Sie an diese wichtige Differentialdiagnose in Haut, Mundhöhle, Leber und Geschlechtsorganen.
Natrium ist das bedeutendste Kation in der extrazellulären Flüssigkeit.
Calcium (Ca) ist zu 98% in den Knochen enthalten und sorgt für deren Stabilität.
Durchfallerkrankungen stellen bei Kleinsäugern ein häufig vorkommendes Problem dar.
Patienten mit unerwünschtem Verhalten werden zumeist erst spät in ihrer Leidensgeschichte in der Praxis vorgestellt, da das Verhalten meist nicht mit einer Erkrankung, sondern ausschließlich mit den Lebensumständen und dem Wesen eines Tieres in Verbindung gebracht wird.
In Deutschland werden aktuell rund 1,6 Millionen Schafe und 170.000 Ziegen gehalten.
Vektorübertragene Infektionen gewinnen in Deutschland bei Hunden und Katzen an Bedeutung aufgrund folgender Ursachen...
Infektionen mit den verschiedenen Erregern des Katzenschnupfenkomplexes treten trotz verfügbarer Impfung immer wieder auf.
Der Körper von Säugetieren ist mit unzähligen Mikroorganismen wie Bakterien, Pilzen, Protozoen und Viren besiedelt.
Diagnostik von Neoplasien im Magen-Darm-Trakt der Katze: eine histologische Untersuchung ist essenziell und wesentliche Grundlage für Prognose und Therapie.
Bei den in Südamerika lebenden Neuweltkameliden werden vier Arten unterschieden...
2019
Zur Beurteilung der Nierenfunktion stehen in der Labordiagnostik verschiedene Parameter zur Verfügung, welche die glomeruläre Filtrationsrate (GFR) gut darstellen.
Eine Hämolyse vermuten wir insbesondere bei regenerativen Anämien, wenn ein Blutverlust ausgeschlossen wurde
Die seit dem 01.03.2018 geltende Neufassung der Tierärztlichen Hausapothekenverordnung (TÄHAV) hat auch bezüglich der Therapie von (Kerato-)Konjunktivitiden einige Fragen aufgeworfen.
Umfangsvermehrungen im Halsbereich – die histologische Untersuchung ist essenziell, auch zur Abklärung seltener Veränderungen wie der plexiformen Vaskulopathie
Sowohl das Übergangszell- als auch das Prostatakarzinom (PCa) des Hundes sind hochmaligne Neoplasien...
Beim erkrankten Meerschweinchen stellt die Labordiagnostik weiterhin eine wichtige Zusatzuntersuchung in der Diagnostik dar.
Neurologische Erkrankungen beim Hund können viele Ursachen haben, u.a. können sie infektiös bedingt sein.
Viele Bereiche des Körpers sind bei Hunden mit den unterschiedlichsten Bakterien besiedelt...
Die Lebenserwartung unserer Haustiere ist in den letzten Jahren aufgrund verschiedener Faktoren gestiegen...
Als Ichthyose (griechisch für „Fisch“ bzw. „Fischschuppe“) wird eine Störung der Keratinisierung und Verhornung der Haut bezeichnet
Erfahren Sie, wie die TÄHAV seit 2018 den Umgang mit Antibiotika und Antibiogrammen in Tierarztpraxen neu regelt.
2018
Im tierärztlichen Alltag begegnen uns auch hin und wieder außergewöhnliche Patienten: Von Frühling bis Herbst werden gelegentlich Wildigel (Europäische Braunbrustigel, Erinaceus europaeus) in der Tierarztpraxis vorgestellt.
Ein erstes Verdachtsmoment ist gegeben, wenn ein Hund oder eine Katze höheren Alters und typischer Rasse mit entsprechenden Symptomen (Polyurie, Polydipsie, Polyphagie) vorgestellt wird.
Die Untersuchung von Bauchhöhlenergüssen ist wichtig zur Abklärung der differentialdiagnostisch in Frage kommenden Erkrankungen.
Im 1. Lebensjahr zeigen die Referenzbereiche einiger Blutparameter bei Hunden und Katzen deutliche Abweichungen von denen adulter Tiere. Die Normalwerte von Welpen können sich vor allem in den ersten Lebenswochen sehr schnell verändern.
Bei der Katze werden drei Blutgruppen routinemäßig bestimmt.
Eine Leukozytose wird als Erhöhung der Anzahl von weißen Blutkörperchen (Leukozyten) im Blut definiert.
Die Zusammensetzung der Harnsteine eines Patienten sollte grundsätzlich analysiert werden, um entscheidende Hinweise für Therapie, Prophylaxe und Prognose zu gewinnen.
Leydigzelltumore, Sertolizelltumore, Seminome – häufige Hodentumore beim älteren Rüden: die Kastration und eine histopathologische Diagnose sind entscheidend.
Immer mehr Besitzer von Hunden und Katzen suchen bei der Ernährung ihrer Haustiere nach Alternativen zum Fertigfutter.
Erkrankungen der unteren Harnwege (FLUTD = Feline Lower Urinary Tract Disease) sind ein häufiger Grund, warum Katzen in der tierärztlichen Praxis vorgestellt werden.
Zahnerkrankungen und Fütterungsfehler sind häufige Ursachen für Durchfall.
2017
Die intestinale Mikrobiota des Hundes setzt sich aus einer Vielzahl an Bakterien, Viren, Pilzen und Protozoen zusammen und stellt ein komplexes Ökosystem dar.
Der verantwortungsvolle Umgang mit Antibiotika ist für die Veterinärmedizin schon lange ein bedeutendes Thema.
Kleine Wiederkäuer sowie Neuweltkameliden (Lamas und Alpakas) werden zum Teil als Nutztiere, zum Teil als Freizeittiere gehalten und stellen die behandelnden TierärztInnen im Bereich der Diagnostik vor verschiedene Herausforderungen.
Bei unseren Katzen kommt eine Dermatophytose relativ häufig vor. Neben Tieren mit verdächtigen klinischen Erscheinungen wie kreisrundem Haarverlust sind gleichzeitig auch klinisch unauffällige Träger vorhanden, die jedoch für gesunde Tiere als Ansteckungsquelle dienen können.
Cortisol, welches in den Nebennieren produziert wird, ist in physiologischen Konzentrationen absolut lebensnotwendig. Cortisol reguliert unter anderem den Metabolismus durch Erhöhung der Glykoneogenese, erhöht die Gefäßreaktivität, reguliert den Wasser- und Elektrolythaushalt und es hat eine anti-inflammatorische Wirkung.
Wie bei Säugetieren ist auch bei Vögeln die Haut wichtiges Schutz- und Sinnesorgan und spiegelt sowohl ein ungestörtes Allgemeinbefinden als auch eine Verminderungen desselben wider.
Diese Übersicht soll Ihnen einen Überblick über die bei Laboklin durchgeführten Allergietests geben, um einen besseren Überblick zu haben, wann welcher Test für Sie im jeweiligen Fall relevant ist.
Für genetische Untersuchungen gibt es einige Spezifika, die es als Tierarzt zu kennen gilt, damit Probennahme und Interpretation von Ergebnissen optimal verlaufen können.
Mit der Änderung der Beziehung vom Gebrauchshund zum Sozialpartner Hund und Katze ist die Erwartung der Tierbesitzer, diese Gefährten möglichst lange und gesund bei sich zu haben, in den Fokus gerückt.
Rabbit Haemorrhagic Disease (RHD), auch Hämorrhagische Kaninchenkrankheit, Chinaseuche oder Virale Hepatitis der Kaninchen genannt...
2016
Erfahren Sie mehr über Tumorgradingsysteme: ein auf morphologischen Kriterien basierendes Hilfsmittel zur besseren Einschätzung der Prognose von Tumoren.
Der Patient Hund mit Problemen im Bereich der Reproduktion ist eher die Ausnahme in der Praxis.
Aussagekräftige Blutergebnisse kann man nur durch geeignetes Probenmaterial erzielen. Hierbei sind die korrekte Probenentnahme, die Bearbeitung und der Versand wichtig.
Um ein aussagekräftiges Ergebnis beim Erregernachweis mittels der bakteriologischen und mykologischen Untersuchung (Kultur) oder mittels Polymerase-Kettenreaktion (PCR) zu bekommen, sind eine adäquate Probenauswahl, Probenentnahme und Versandweise wichtig.
Bei einigen Erkrankungen bzw. beim Einsatz bestimmter Medikamente kann eine Therapiekontrolle durchgeführt werden.
Histologie, Zytologie und Immunhistologie: erfahren Sie hier wichtige Fakten zur Probennahme, Methodik und speziellen Leistungen in der Pathologie.
In diesem Laboklin aktuell werden die Veränderungen in der Taxonomie, zur Verbreitung, Therapie und Prophylaxe der kaninen Babesiose (alt: Piroplasmose) dargestellt.
Im Bereich der klinischen Diagnostik hat die Polymerase Kettenreaktion (PCR) längst Einzug gehalten und gewinnt zunehmend an Bedeutung.
Das Pankreas ist ein sehr wichtiges Verdauungsorgan bei Hund und Katze und besteht aus einem exokrinen und einem endokrinen Teil.
Tupfer, Aspirations- und Abklatschpräparate – das minimalinvasive und schnelle Verfahren der zytologischen Untersuchung ist auch bei Reptilien geeignet.
2015
Verdauungsstörungen sind ein häufiger Grund, warum Patienten in der Tierarztpraxis vorgestellt werden. Während akute Diarrhöen häufig auch ohne eine Ursachenforschung durch einfache Maßnahmen wie Diät und Flüssigkeitsersatz zum Abheilen kommen, gestaltet sich die Ursachenforschung bei chronischen oder chronisch rezidivierenden Diarrhöen weitaus schwieriger.
Als DNA-Analyse (synonym: DNA-Test, DNS-Analyse, DNS-Test, Genanalyse oder Gentest) werden molekularbiologische Verfahren bezeichnet, welche das genetische Erbgut (DNA) untersuchen, um Rückschlüsse auf verschiedene genetische Aspekte eines Individuums ziehen zu können (wikipedia).
Sie haben Ausstrichpräparate hergestellt? – Erhalten Sie hier einen Überblick über die systematische Auswertung zytologischer Präparate in der Tiermedizin.
Erkrankungen des Harntraktes sind ein häufiger Grund für die Vorstellung von Hunden und Katzen in der Praxis. Die klinischen Symptome (u.a. Hämaturie, Strangurie, Dysurie, Periurie) sind dabei sehr unspezifisch und stehen für eine Vielzahl von Erkrankungen.
Mesenchymale Neoplasien mit spindelzelliger Morphologie – histopathologische und immunhistologische Diagnostik, Therapie und Prognose von Spindelzellsarkomen.
Magen-Darm-Bioptate bei verschiedenen Krankheitsbildern inklusive Checkliste für eine optimale Probenentnahme. So erhalten Sie aussagekräftige Ergebnisse.
Die Abkürzung FACS steht für fluorescenceactivated cell sorting.
Die beiden wichtigsten Retrovirusinfektionen der Katze, FIV und FeLV, begleiten einen durch die tägliche Praxis und den Laboralltag.
Dermatophyten sind Fadenpilze und stammen teleomorph aus dem Reich Eumycota, der Abteilung Ascomycota, der Unterabteilung Euascomycota, der Ordnung Onygenales, der Familie Arthrodermataceae und der Gattung Arthroderma.
Der Einsatz von Antibiotika zur Therapie bakterieller Infektionen in der tierärztlichen Praxis ist unverzichtbar und ein wesentlicher Bestandteil der täglichen Arbeit.
2014
Tumoren der Nieren sind bei Hund und Katze seltener als Tumoren der Harnblase.
Dermatophyten sind fadenförmige Pilze, die Hautveränderungen bei Mensch und Tier auslösen können. Die Erkrankung wird als Dermatophytose bezeichnet. Die Pilze nutzen Keratin als Kohlenstoffquelle und besiedeln keratinisiertes Gewebe (Haare, Haut, Krallen).
Schildkröten sind sehr beliebte Haustiere, die bei guter Haltung viele Jahrzehnte leben und sogar über Generationen in Familien gehalten werden können. Aus diesem Grund entsteht oft eine enge Bindung zwischen Halter und Tier.
Bei Leukämien handelt es sich um eine neoplastische Proliferation meist einer Leukozytenpopulation im Knochenmark. Diese macht sich dann als ausgeprägte Leukozytose im peripheren Blut bemerkbar.
2013
Das Pankreas hat vielfältige lebenswichtige Aufgaben im Stoffwechsel. Der exokrine Anteil sezerniert Verdauungsenzyme und ist somit für die Verwertung der Nahrungsbestandteile essentiell.
Die diagnostische Abklärung von lymphoproliferativen Prozessen ist eine häufige Fragestellung in der Kleintierpraxis. Dabei geht es zum einen darum ein malignes Lymphom/ eine Leukämie zu bestätigen oder weitgehend auszuschließen, zum anderen ist es im Falle eines Tumors von prognostischem Interesse zwischen einem B- und einem T-Zelllymphom zu differenzieren.
Da die Leber an vielen Körperfunktionen beteiligt ist, sind Lebererkrankungen mit einer Vielzahl von klinischen Symptomen und auch diversen Laborwertveränderungen verbunden.
Bei der Leptospirose handelt es sich um eine Zoonose mit weltweiter Verbreitung. Der Erreger ist ein gram-negatives, schraubenförmiges Bakterium aus der Gruppe der Spirochäten.
Nicht nur in der Nutztierpraxis, auch in der Kleintier- und Pferdepraxis werden mittlerweile vermehrt multiresistente Keime kultiviert und bereiten bei der antibiotischen Therapie zunehmend Probleme.
2012
Fast täglich wird in den Medien über neue Nachrichten zu nosokomialen Infektionen berichtet
Die unter dem Namen „Zwingerhusten“ (Infektiöse canine Laryngotracheitis, „Kennel Cough“) bekannte Atemwegserkrankung des Hundes ist gekennzeichnet durch das akute Auftreten eines extrem rauen, teilweise krampfartigen Hustens.
2011
Das Wissen über die Erkrankungen der Schilddrüse bei Hund und Katze gehört bei den meisten Praktikern mit Schwerpunkt Kleintiere zum Standard.
Die ESBL (extended spectrum beta-lactamase) beschreibt eine Resistenzeigenschaft von Bakterien.
Die zytologische Untersuchung ist eine minimalinvasive und kosteneffektive diagnostische Maßnahme
Der equine Cushing ist ja schon längere Zeit Gegenstand intensiver wissenschaftlicher Bemühungen, die sich vor allem auf die ätiologische Abklärung dieser schon immer existierenden Erkrankung konzentrierten.
2010
Die Zunahme der Reisetätigkeit von Haustieren und der Import von Tieren aus den verschiedensten Teilen dieser Erde, stellen uns Tierärzte immer wieder vor neue Herausforderungen.
Diarrhoe ist eines der Hauptprobleme beim Fohlen. So entwickeln gemäß verschiedener Studien ca. 70 % aller Fohlen im ersten Lebenshalbjahr Durchfall, die Mortalität ist dabei aber gering.
Mangelnde Literatur, die besondere Problematik in der Diagnostik und unzureichende Kenntnisse über Infektionen strikter Anaerobier führten dazu, dass in der letzten Zeit diese Bakterien fast in Vergessenheit geraten sind
2009
Vor mehr als zwei Jahrzehnten wurde bei Colliehunden erstmals ein Krankheitsbild beobachtet, bei dem es infolge der Behandlung mit dem Antiparasitikum Ivermectin zur Ausprägung schwerer neurologischer Symptome kam
Kaninchen und Meerschweinchen erfreuen sich als Haus- und Heimtiere zunehmender Beliebtheit und gehören damit vermehrt zum Klientel der Tierarztpraxen
Hauptursache von Fruchtbarkeitsstörungen der Stute sind Genitalbesiedlungen mit fakultativ pathogenen Keimen, deren Krankheitsbilder klinisch nicht differenziert werden können und die häufig sogar subklinisch verlaufen.
Das Kaninchen hat sich in den letzten Jahren zu einem sehr beliebten Heimtier entwickelt. Dementsprechend gestiegen ist die Bereitschaft der Besitzer alles im Falle einer Erkrankung für ihr Tier zu tun
Hypoadrenocortizismus (Morbus Addison) reflektiert den Zustand des Organismus infolge einer mangelnden Produktion / Sekretion von Glucocorticoiden bzw. Mineralocorticoiden duch die Nebennierenrinde.
Die glomeruläre Filtrationsrate (GFR) reflektiert als Basisfunktion der Niere frühzeitig und am deutlichsten eine Funktionseinschränkung des Organs.
2008
Erfahren Sie, wie das Trichogramm als wertvolles Diagnostikverfahren bei Haarverlust, Milben und Pilzerkrankungen eingesetzt wird.
Bei der Borreliose handelt es sich um eine von Vektoren (Ixodes ricinus) übertragene bakterielle Infektion
Mit dem LABOKLIN aktuell 6/2007 berichteten wir im vergangenen Jahr über Harnsteinbefunde beim Hund. Viele allgemeine Aussagen gelten ebenso für die Katze.